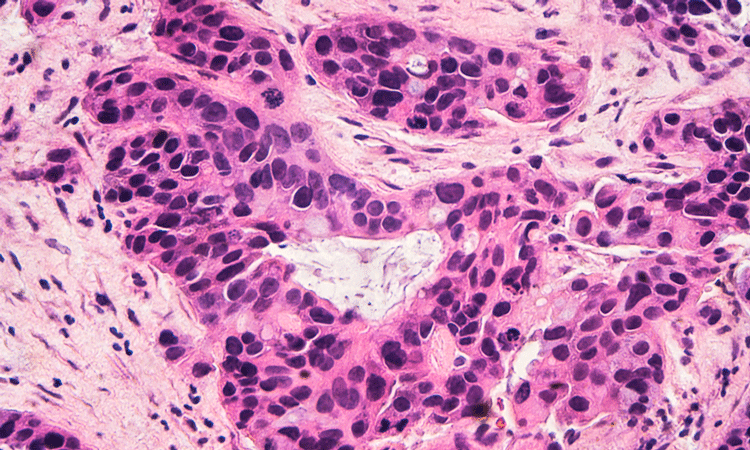

Animal study shows abnormal activity of brain circuit causes anorexia
Researchers have found that genetically and pharmacologically restoring the normal activity of the brain circuit improved anorexia, opening the possibility of developing a treatment strategy for affected individuals in the future.